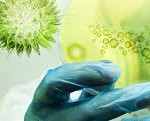

In this special day, Creative Biolabs opens its first blog. With this blog, we are going to explore more with you in the field of antibody and antibody engineering. Let’s get started with the real thing.
In this special day, Creative Biolabs opens its first blog. With this blog, we are going to explore more with you in the field of antibody and antibody engineering. Let’s get started with the real thing.
How much do you know about Creative Biolabs?
In the year of 2005, a group of scientists with the common ambition of conquering intractable diseases like cancer formed Creative Biolabs in Shirley, New York. With years of efforts, it has now developed into a global biotech company with offices in Germany, UK and China, serving laboratories, individual scientists and institutes around the world.
Creative Biolabs is specialized in providing custom biotechnology and pharmaceutical services that cover the full scope of biotechnology needs of early drug discovery and drug development. As a trusted provider of the most cost-effective outsourcing solutions, Creative Biolabs has been working for a large number of clients from biotechnology and pharmaceutical companies as well as government and academic research laboratories all over the world.
The Mission of Creative Biolabs
Thanks to the encouragement of increasing market demands, Creative Biolabs has already updated its technology platform. Our mission is to meet all the specific requirements from researchers and scientists by providing them with accesses to the cutting-edge technologies in the field of antibody. Of course, quality and efficiency are what we are up to.
What you can expect on this blog?
Everything interesting or serious may be posted here. We are going to present you industry news, the updated biotechnologies, the hottest research fields recently, the stories of scientists or researchers who have done great contribution to the development of Biology, and more.
